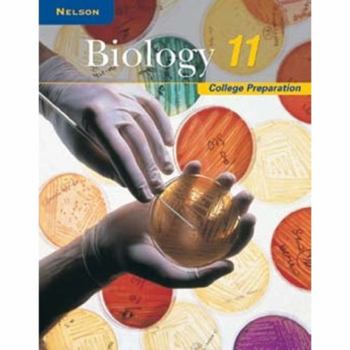
Paperback Biology 11: College Preparation, Student Edition Book

Biology 11: College Preparation, Student Edition
No Synopsis Available.
Format:Paperback
Language:English
ISBN:1259022641
ISBN13:9781259022647
Release Date:November 2012
Publisher:McGraw-Hill Ryerson
Length:512 Pages
Weight:2.85 lbs.
Dimensions:0.4" x 4.4" x 3.4"
Customer Reviews
0 rating